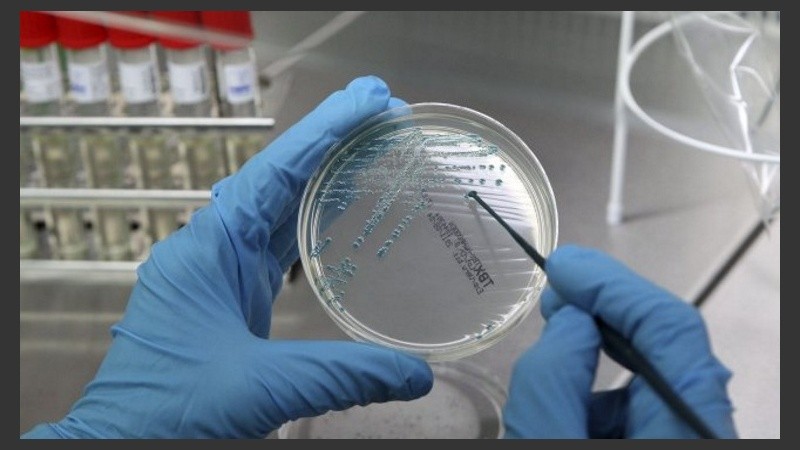
El cáncer de hígado primario es la segunda causa de muerte por cáncer en el mundo.

Científicos de la Escuela Politécnica Federal de Lausana, Suiza, han encontrado, en pruebas con ratones, la forma de dejar morir de hambre a las células cancerígenas del hígado al bloquear una proteína, mientras que respeta a la células normales.
Este descubrimiento, que publica la revista Genes & Development, abre la puerta a la nuevos tratamientos para el cáncer de hígado, según un comunicado de la escuela.
El cáncer de hígado primario es la segunda causa de muerte por cáncer en el mundo y los actuales tratamientos son muy limitados, pero los expertos saben que las células de ese órgano son "especialmente adictas" a la glutamina, un aminoácido que propicia su proliferación.
Los científicos han descubierto ahora que una proteína del hígado denominada receptor homólogo hepático 1 (LRH-1) es responsable de la digestión de la glutamina, que la descompone en moléculas más pequeñas, las cuales son consumidas "con avidez" por la células cancerígenas del hígado, lo que ayuda a su proliferación.
Por ello, bloquear la LRH-1 hace que las células cancerígenas se mueran de hambre y se reduce en gran medida el desarrollo del cáncer en ratones, mientras se protege a las células normales.
En el estudio, los científicos, liderados por Kristina Schoonjans, interrumpieron la función del LRH-1 en el hígado de ratones a través de la manipulación genética. Tras exponer a los animales a químicos cancerígenos, el hígado de aquellos que habían sido manipulados mostraron una desarrollo mucho menor de tumores.
De esta manera, "inhibir la LRH-1 puede ser una forma eficaz de matar de hambre solo a las células cancerígenas del hígado, mientras las normales quedan intactas", dijo Schoonjans. El descubrimiento puede suponer el desarrollo de nuevos medicamentos que tengan como diana objetivo el LRH-1 para tratar de manera eficaz los cánceres de hígado.
El equipo trabaja ahora en identificar nuevos agentes quimioterapéuticos para tratar el cáncer de hígado desarrollando componentes específicos que inhiban el LRH-1 y tiene la esperanza de que estos descubrimientos se extiendan a otros tipos de cánceres que también son comunes como el de páncreas o el de ovarios.